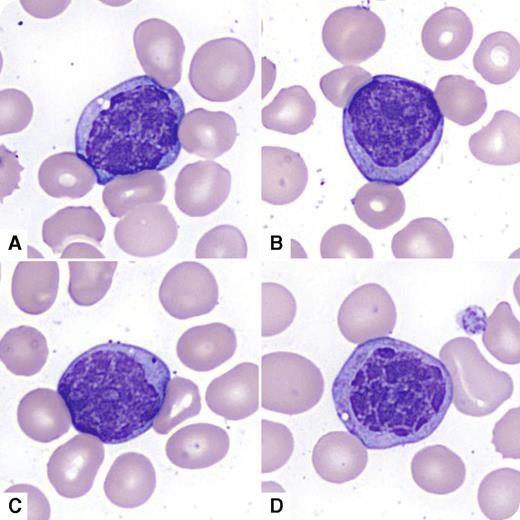
A 73-year-old man presented with fatigue and dyspnea and was found to have pancytopenia. His complete blood count showed hemoglobin of 81 g/L, mean corpuscular volume of 96 fL, platelet count of 28 × 109/L, white blood cell count of 12.4 × 109/L, with neutrophils of 1.0 × 109/L. He previously had mild macrocytic anemia (since 2008). He had mild splenomegaly with no lymphadenopathy. His peripheral blood smear revealed frequent mononuclear atypical cells lacking prominent nucleoli with abnormal nuclear chromatin clumping (large blocks of chromatin separated by clear zones) that the CellaVision DM96 system misclassified as promyelocytes (panels A-B), myelocytes (panel C), and monocytes (panel D). The bone marrow examination revealed acute myeloid leukemia with myelodysplasia-related changes, with marked chromatin clumping in the CD34+ cells. Flow cytometry confirmed dimCD45/CD34/CD117/CD13/CD33/HLA-Dr positive myeloid blasts (71%) heterogeneously coexpressing CD7 and CD11b. Cytogenetic studies revealed monosomy 20 and inversion 7. / Abnormal chromatin clumping in cells of myeloid lineage has been described in myelodysplasia, BCR-ABL1 negative atypical chronic myelogenous leukemia, drug effect with mycophenolate mofetil, and acute leukemia with trilineage dysplasia. In our patient, an abnormal nuclear chromatin pattern altered the appearance of myeloblasts in the peripheral blood, creating a more “condensed” chromatin appearance that mimicked chronic lymphocytic leukemia, peripheralized lymphoma, or chronic myelomonocytic leukemia.

A 73-year-old man presented with fatigue and dyspnea and was found to have pancytopenia. His complete blood count showed hemoglobin of 81 g/L, mean corpuscular volume of 96 fL, platelet count of 28 × 109/L, white blood cell count of 12.4 × 109/L, with neutrophils of 1.0 × 109/L. He previously had mild macrocytic anemia (since 2008). He had mild splenomegaly with no lymphadenopathy. His peripheral blood smear revealed frequent mononuclear atypical cells lacking prominent nucleoli with abnormal nuclear chromatin clumping (large blocks of chromatin separated by clear zones) that the CellaVision DM96 system misclassified as promyelocytes (panels A-B), myelocytes (panel C), and monocytes (panel D). The bone marrow examination revealed acute myeloid leukemia with myelodysplasia-related changes, with marked chromatin clumping in the CD34+ cells. Flow cytometry confirmed dimCD45/CD34/CD117/CD13/CD33/HLA-Dr positive myeloid blasts (71%) heterogeneously coexpressing CD7 and CD11b. Cytogenetic studies revealed monosomy 20 and inversion 7.
Abnormal chromatin clumping in cells of myeloid lineage has been described in myelodysplasia, BCR-ABL1 negative atypical chronic myelogenous leukemia, drug effect with mycophenolate mofetil, and acute leukemia with trilineage dysplasia. In our patient, an abnormal nuclear chromatin pattern altered the appearance of myeloblasts in the peripheral blood, creating a more “condensed” chromatin appearance that mimicked chronic lymphocytic leukemia, peripheralized lymphoma, or chronic myelomonocytic leukemia.
A 73-year-old man presented with fatigue and dyspnea and was found to have pancytopenia. His complete blood count showed hemoglobin of 81 g/L, mean corpuscular volume of 96 fL, platelet count of 28 × 109/L, white blood cell count of 12.4 × 109/L, with neutrophils of 1.0 × 109/L. He previously had mild macrocytic anemia (since 2008). He had mild splenomegaly with no lymphadenopathy. His peripheral blood smear revealed frequent mononuclear atypical cells lacking prominent nucleoli with abnormal nuclear chromatin clumping (large blocks of chromatin separated by clear zones) that the CellaVision DM96 system misclassified as promyelocytes (panels A-B), myelocytes (panel C), and monocytes (panel D). The bone marrow examination revealed acute myeloid leukemia with myelodysplasia-related changes, with marked chromatin clumping in the CD34+ cells. Flow cytometry confirmed dimCD45/CD34/CD117/CD13/CD33/HLA-Dr positive myeloid blasts (71%) heterogeneously coexpressing CD7 and CD11b. Cytogenetic studies revealed monosomy 20 and inversion 7.
Abnormal chromatin clumping in cells of myeloid lineage has been described in myelodysplasia, BCR-ABL1 negative atypical chronic myelogenous leukemia, drug effect with mycophenolate mofetil, and acute leukemia with trilineage dysplasia. In our patient, an abnormal nuclear chromatin pattern altered the appearance of myeloblasts in the peripheral blood, creating a more “condensed” chromatin appearance that mimicked chronic lymphocytic leukemia, peripheralized lymphoma, or chronic myelomonocytic leukemia.
For additional images, visit the ASH IMAGE BANK, a reference and teaching tool that is continually updated with new atlas and case study images. For more information visit http://imagebank.hematology.org.